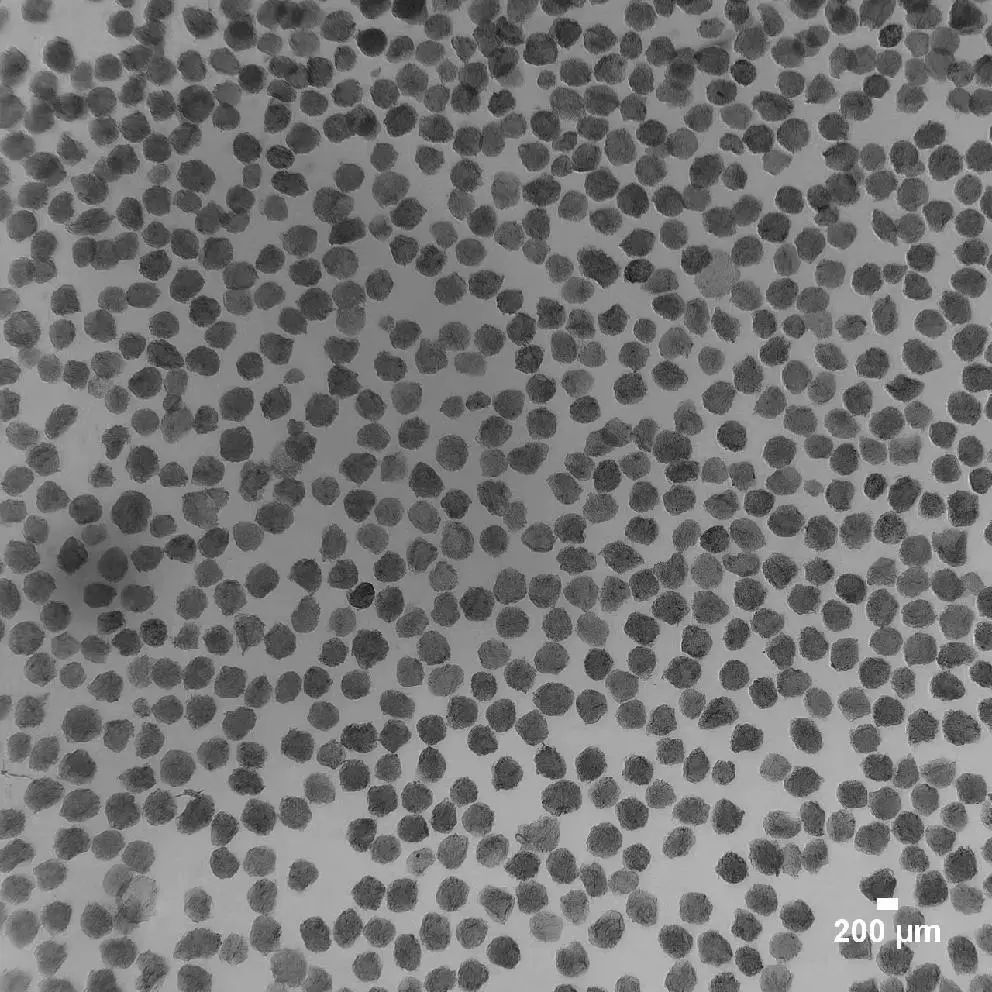

专利示意图
一、技术领域
生物医学材料技术领域
二、专利介绍
1.专利信息
专利类型:发明
专利权人:清华大学深圳国际研究生院
申请号:2023106924657
发明人:吴耀炯、李小松、安子炫、卢瑞卿
2.专利说明书摘要
本发明公开了一种多孔胶原蛋白三维细胞微载体的制备方法与应用,所述制备方法具体包括:首先将胶原蛋白、可降解生物大分子和弱酸溶液混合,得到水相原液;然后将有机溶剂、非离子型表面活化剂和交联剂混合,得到油相原液;最后以水相原液为制备原料,以油相原液为收集液进行喷雾造粒,得到微球颗粒,经清洗、冷冻干燥后即可,其中水相原液的电导率为200~3000uS/cm、粘度为1000~10000cP。采用本发明方法制得的三维细胞微载体粒径均匀,介于200~1200μm之间,孔隙率介于30~90%之间,表面孔隙介于20~80μm之间,且具有优异的机械强度,可广泛应用于细胞培养、医美填充与体内局部注射等。
3.创新点
基于上述问题,本工艺生产的多孔胶原蛋白三维细胞微载体具有强大的多功能性,同一种微载体可支持细胞培养、医美填充与体内局部注射等多种用途;可用对细胞温和的酶在短时间内降解,实现细胞的高回收率和高活率;具有较高的机械强度,可在体外培养过程和体内给药后良好的保护负载细胞,体内可较长时间维持主体结构;本工艺基于静电喷雾技术和乳化法的结合,工艺参数灵活,多项工艺具有通用性,只需要调节简单的参数就可以生产不同规格的微载体,产量具有极高的放大潜能,工艺放大简单,成本可得到有效的控制。
4.痛点问题
随着细胞生物学与生物材料学的发展,微载体的重要性正被逐渐重视,并被用作干细胞的规模化培养、医美填充物和局部注射治疗疾病等用途,但目前市面上的微载体存在诸多不足,无法满足主要市场对微载体的功能需求,这些短板主要包括:
(1)微载体功能较为单一,比如只能用于细胞培养,不能满足局部注射需求;
(2)收获方式复杂,多数微载体本身无法降解,需要通过胰酶消化后过滤的方式收集细胞,造成细胞的高丢失率和低活率;
(3)微载体机械强度差,注射入体内后降解速度过快,无法进行组织长期填充或为干细胞提供稳定的支撑与保护;
(4)微载体产量较低,工艺灵活性差,放大生产难度大,导致产品价格相对高昂。
5.技术优势
(1)本发明首次将静电喷雾与乳化法联用,采用了静电喷雾均匀制粒与乳化法快速交联的优点,解决了传统乳化法无法制备均匀微球的技术难点,提供了第一种可稳定制备均匀大小胶原微球的工艺;
(2)本发明首次提出适配静电喷雾法的原料关键参数,比如电导率和粘度,以及提出影响该参数的关键因素,如醋酸浓度/原料浓度和种类;
(3)本发明可制备出球形度高的微球,解决了传统乳化法只能制备圆饼的问题,进一步提高了微球的应用场景;
(4)本发明有效提高了微球的机械强度,负载细胞后可在动物体内可有效保留21天以上;
(5)本发明适合细胞培养,可有效促进细胞贴附和细胞增殖,3h细胞贴附率>90%,3d细胞增殖率>10倍,各项指标均高于或等同于市面上畅销产品华龛微载体;
(6)本发明工艺简单,可重复性极强,工艺灵活性强,仅需要通过调节制备参数即可获得不同粒径大小的均匀球形微载体,具有极大的工业化应用前景。
三、产业化信息
1.应用场景
(1)细胞微载体;
(2)负载细胞做组织工程材料;
(3)面部疤痕填充;
(4)不规则伤口填充。
2.商业价值
(1)细胞治疗行业,本微载体可有效促进细胞的贴附与增殖,在对细胞活力影响较小的酶作用下可完全降解,适合搭配生物反应器进行细胞的逐级扩增,使整个工艺更加的自动化与标准化;
(2)医疗行业,微载体负载间充质干细胞/软骨细胞或其他体细胞进行局部注射,可实现细胞增殖与治疗平台一体化,微载体可支持细胞在体内完成较长时间的存留,促进细胞长时间分泌细胞因子或进行分化,从而用更小的细胞剂量完成更好的治疗效果;
(3)美容行业,微载体可单独或与干细胞结合用于医美领域,完成面部凹陷填充和疤痕修复。
3.发展规划
该技术可采用并联扩大,将产量从20万颗/h提升10倍到100倍以上,同时进一步优化工艺,完成各种应用场景的功能化模块设计。
4.合作方式
面议
注:所有成果未经授权,请勿转载
联系方式:ttc@sz.tsinghua.edu.cn






